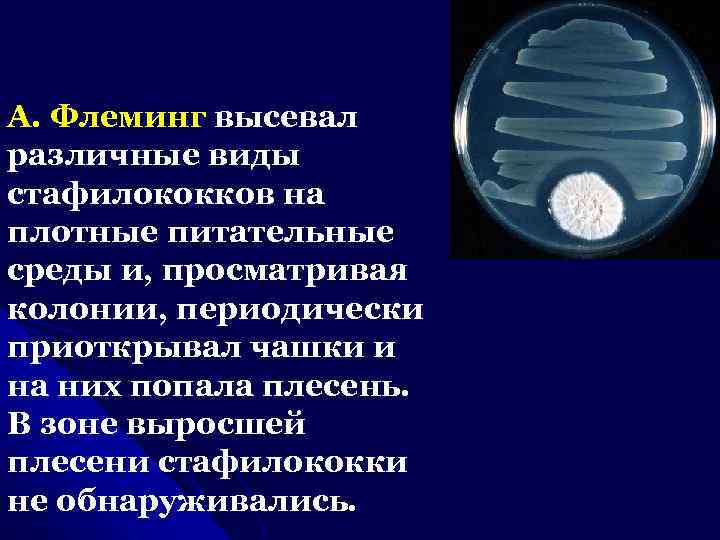
А. Флеминг высевал различные виды стафилококков на плотные питательные среды и, просматривая колонии, периодически

Антибиотики 2009 сокр. синяя.ppt
- Количество слайдов: 57

АНТИБИОТИКИ Лектор: ассистент каф. микробиологии Т. А. Черепанова

ИСТОРИЯ ОТКРЫТИЯ АНТИБИОТИКОВ Многие исследователи рассматривали явление антагонизма как проявление борьбы за существование. В 1877 году французский ученый Л. Пастер предсказал, что когда-нибудь медицина сможет широко использовать это явление в своих целях для лечения инфекционных заболеваний. Близкий друг и соратник Л. Пастера И. И. Мечников высказал предположение, что одни микробы подавляют жизнедеятельность других за счет выделения каких-то ядовитых веществ. Это явление получило название антибиоза. Впоследствии предсказанные И. И. Мечниковым вещества были выделены в чистом виде. В 1942 году С. А. Ваксманом названы антибиотиками.

В 1871 г. профессор Военномедицинской академии В. А. Монасеин представил материалы о способности плесени уничтожать микроорганизмы. В 1872 г. профессор А. Г. Полотебнов сообщил результаты лечения гнойных ран порошком из спор грибов родов Penicillium и Aspergillus

Пауль Эрлих предложил термин «химиотерапия» . Принцип «волшебной пули» Эрлиха – убить живое в живом, не вредя живому. В 1896 г. итальянский врач Б. Гозио выделил культуру зеленого микроскопического гриба из заплесневевших зерен риса, который антибиотически действовал на бактерии. Он получил первый антибиотик в чистом виде.
А. Флеминг высевал различные виды стафилококков на плотные питательные среды и, просматривая колонии, периодически приоткрывал чашки и на них попала плесень. В зоне выросшей плесени стафилококки не обнаруживались.

1939 г. Г. У. Флори, Э. Б. Чейном и Н. Г. Хитли -специалисты Оксфордского университета В годы второй мировой войны ученые получили первые граммы "сырого" пенициллина. Этот препарат обладал мощным бактерицидным действием. В последующем была расшифрована химическая структура пенициллина, что создавало возможность для получения его синтетическим способом. Пенициллин испытали на первом пациенте 12 февраля 1941 года. Академик АМН СССР З. В. Ермольева совместно с Т. М. Балезиной получили наиболее продуктивный штамм микроскопического гриба - Penicillium cristosum.

С. Л. Ваксманом в 1942 году был получен стрептомицин. В 1945 и 1947 г. г. были получены хлортетрациклин и хлорамфеникол. Бротцу в 1948 году на побережье Сардинии нашел плесень из рода Cephalosporium, из которой был выделен первый цефалоспорин. Вскоре, антибиотики стали появляться как из рога изобилия, сегодня их количество превышает 6 тысяч, хотя только 2 -3% из них используют с лечебной целью.

Антибиотики, применяемые в клинике, чаше выделяются не из плесеней, а из актиномицетов. Из них получают левомицетин, тетрациклин, стрептомицин, рифампицин и некоторые другие антибиотики. Из эубактерий получают бацитрацин, грамицидин и др. Таким образом, первоначально антибиотики представляли собой вещества природного происхождения, обладающие биологической активностью. В настоящее время они могут быть получены не только из микробов, а из растений (аллицин и др. ), животных тканей (эритрин, экмолин) и синтетическим путем.

Антибиотики это химиотерапевтические вещества, образуемые микроорганизмами, или полученные из иных природных источников, а также их производные и синтетические продукты, обладающие способностью избирательно подавлять в организме больного возбудителей заболеваний или задерживать развитие злокачественных новообразований.

Медицина предъявляет следующие требования к антимикробным препаратам: 1. Высокая избирательность антимикробного эффекта в дозах, нетоксичных для организма. 2. Отсутствие или медленное развитие резистентности возбудителя к препарату в процессе его применения. 3. Сохранение антимикробного эффекта в жидкостях и тканях организма, отсутствие или низкий уровень инактивации белками сыворотки крови, тканевыми энзимами. 4. Хорошее всасывание, распределение и выведение препарата, обеспечивающие терапевтическую концентрацию в крови, тканях и жидкостях макроорганизма. 5. Удобная лекарственная форма.

Антибиотические вещества относятся к этиотропным средствам, которые избирательно подавляют или прекращают рост возбудителей болезней в организме больного. Ввиду того, что по физико-химическим свойствам многие антибиотики принадлежат к различным классам соединений, конкретный механизм антимикробного эффекта может быть различными.

По типам антимикробного действия антибиотики распределяются на бактерицидные и бактериостатические. При лечении большинства инфекций, особенно со средней тяжестью течения, для обеспечения полного терапевтического эффекта достаточно бактериостатического действия препарата. Защитные силы организма больного реализуют механизмы, позволяющие освободиться от возбудителей заболевания.

Бактерицидный тип действия характерен для пенициллинов, стрептомицина, неомицина, канамицина. Все тетрациклиновые антибиотики, левомицетин, макролиды в обычных применяемых дозах действуют бактериостатически.

Основой терапевтического действия антибактериальных препаратов является подавление жизнедеятельности возбудителя инфекционной болезни в результате угнетения специфического для микроорганизмов метаболического процесса. Угнетение происходит в результате связывания антибиотика с мишенью, в качестве которой может выступать любой фермент или структурная молекула микроорганизма.

Каждый антибиотик может подавлять ряд метаболических реакций в зависимости от его концентрации в среде, причем с увеличением концентрации антибиотика затрагивается все большее число метаболических процессов микробной клетки. Блокирование одной из реакций может привести вторично к подавлению других процессов обмена, что обуславливает множественность точек приложения антимикробного действия препаратов.

Классификация антибиотиков как специфических ингибиторов некоторых биохимических процессов, происходящих в микроорганизмах и опухолевых клетках.

I. Специфические ингибиторы синтеза клеточной стенки микроорганизмов. 2. Aнтибиотики, нарушающие молекулярную организацию и функции клеточных мембран. 3. Антибиотики, подавляющие синтез белка на уровне рибосом. 4. Ингибиторы транскрипции и синтеза нуклеиновых кислот.


I. Специфические ингибиторы синтеза клеточной стенки микроорганизмов: • Беталактамы - пенициллины и цефалоспорины, монобактамы, карбапенемы. • Бацитрацин. • Циклосерин. • Гликопептиды. • Фосфомицин.

Основу клеточной стенки бактерий (прокариотов) составляет пептидогликан. В эукариотических клетках пептидогликан отсутствует. Многие антибиотики этой группы являются селективными ингибиторами синтеза мукопептидов клеточной стенки бактерий, находящихся в стадии размножения.


Мишенями действия антибиотиков этой группы являются энзимы клеточной стенки микроорганизмов. Антипептидогликановые антибиотики лишь запускают процесс уничтожения микробов. Завершение этого процесса обеспечивают собственные ферменты бактерий – аутолизины.

Физиологическая функция аутолизинов состоит в контролируемом расщеплении пептидогликана при делении клеток. Антибиотики снимают этот контроль. Инактивация ферментов, участвующих в синтезе пептидогликана и снятие контроля утолитических ферментов приводит к быстрому разрушению пептидогликанов и гибели клетки.

β- лактамные антибиотики ПЕНИЦИЛЛИНЫ 1. Природные пенициллины • бензилпенициллин • феноксиметилпенициллин 2. Полусинтетические пенициллины 1 -4 го поколений

Основная мишень пенициллинов – пенициллинсвязывающие белки (РВР) или транспептидазы, ответственные за «сшивание» пептидогликановых цепей. В настоящее время описано 6 типов РВР. Мишенями пенициллина также являются карбоксипептидаза, участвующая в синтезе пептидогликана и гликозидаза, которая участвует в синтезе полисахаридных цепей клеточной стенки.


При относительно низких концентрациях пенициллина подавляется активность транспептидазы, которая опосредует соединение аланина и глицина на терминальных участках пептидной цепи. Это приводит к образованию поперечных перегородок в клетках, деление в них подавляется, за счет дисбаланса в росте в длину и толщину происходит удлинение и образование нитеобразных форм.

Под воздействием высоких концентраций пенициллина подавляется активность гликозидазы, образование нитевидных форм прекращается, синтез клеточной стенки полностью блокируется. При одновременном воздействии антибиотика на несколько энзимов проявляется классический бактерицидный эффект.

Формирование резистентности Структурной основой пенициллинов служит 6 -аминопенициллановая кислота. Бактериальные β - лактамазы, расщепляя β- лактамное кольцо антибиотика, переводят его в неактивную пенициллановую кислоту, не обладающую антимикробной активностью.

Для защиты от β- лактамаз в антибиотики вводят дополнительное β- лактамное кольцо, которое связывает β- лактамазы и защищает молекулу антибиотика от инактивации. Эту защиту осуществляет клавулановая кислота, сульбактам. «Защищенные» пенициллины – амоксициллин с клавулановой кислотой (аугментин, амоксиклав), ампициллин с сульбактамом (уназин), тикарциллин с клавулановой кислотой и т. п.


Цефалоспорины Молекула цефалоспоринов содержит β-лактамное кольцо более устойчивое (по сравнению с пенициллинами) к действию β-лактамаз и других бактериальных ферментов. Спектр активности цефалоспоринов охватывает многие грамотрицательные микроорганизмы. Они нарушают синтез клеточной стенки бактерий за счёт угнетения транспептидазы.

В настоящее время создано более 50 препаратов цефалоспоринов, которые представлены 4 поколениями и отличаются по спектру антимикробного действия и устойчивости к βлактамазам.

Монобактамы Устойчивы к β-лактамазам. Отличаются высокой аффинностью (выражение прочности связи структур) к РВР-3. Карбапенемы Имеют самый широкий спектр действия и высокую бактерицидную активность среди всех антибиотиков, содержащих β-лактамное кольцо. Активны против стафилококков.

Aнтибиотики, нарушающие молекулярную организацию и функции клеточных мембран: поликсимины, полиены, нитрофураны грамицидин, азольные производные (клотримазол, миконазол, кетоконазол, флоконазол и др. ).

Полимиксины повреждают ЦПМ (цитоплазматическую мембрану) чувствительных бактериальных клеток и необратимо связываются с ней. Молекулы полимиксинов реагируют с анионным фосфолипидным слоем мембраны (как катионные детергенты). Наступающее при этом нарушение осмотических барьеров клетки приводит к ее лизису. Токсичность полимиксинов также обусловлена их связыванием с мембранами животных клеток. Спектр бактерицидной активности включает грамотрицательную микрофлору.

Полиены – антибиотики полиеновой структуры (нистатин, амфотерицин В и др. ) нарушают осмотический барьер клетки. Полиены связываются с эргостеролом - основным компонентом мембраны дрожжей, грибов и простейших (в клетках млекопитающих доминирует холестерол), что повышает ее проницаемость и приводит к потере низкомолекулярных соединений.

Азольные производные ингибируют цитохром Р-450 деметилазу (ключевой фермент биосинтеза эргостерола). Грамицидины – полипептидные антибиотики, нарушающие целостность ЦПМ, применяются ограниченно как бактериостатические средства при инфекциях, вызванных грамположительными кокками и бациллами.

Антибиотики, подавляющие синтез белка на уровне рибосом:

Этот тип механизма действия свойственен широко используемым в клинике группам антибиотикам: 1. хлорамфениколу 2. аминогликозидам 3. тетрациклинам 4. макролидам

Аминогликозиды и тетрациклины связываются с 30 S-субъединицей, нарушая образование инициаторного рибосомального комплекса. Тетрациклины оказывают бактериостатический эффект. Аминогликозиды убивают бактерии, вызывая образование функционально непригодных 70 S- рибосом, а также извращая считывание информации с матричной РНК.

Аминогликозиды позволяют получить быстрый антимикробный эффект, показаны при резистентности к другим препаратам. Они проявляют синергизм с другими антибиотиками, в первую очередь с β-лактамами, но почти не всасываются приеме внутрь. Обладают нейро - и нефротоксичностью.

Макролиды, хлорамфеникол, линкомицин соединяются с 50 S субъединицей вблизи сайта, фиксирующего аминоацил-т РНК. Это обрывает элонгацию пептидных связей. Здесь прекращается уже начавшийся цикл. После удаления антибиотика процесс возобновляется, т. е. эффект бактериостатический. Хлорамфеникол (левомицетин) – единственный природный антибиотик, содержащий нитробензен, обладающий токсичностью для животных клеток.

Макролиды Относятся к бактериостатическим препаратам, но в высоких концентрациях могут оказывать бактерицидное действие. Воздействуют на быстрорастущие клетки, из организма выводятся медленно, могут оказывать постбиотичекий эффект (особенно макропен повышает активность Ткиллеров).

Ингибиторы транскрипции и синтеза нуклеиновых кислот • Ингибиторы синтеза ДНК на уровне ДНК – гиразы (хинолоны) • Ингибиторы синтеза ДНК на уровне дигидрофолат редуктазы диаминопиримидины (ко-тримоксазол) • Ингибиторы синтеза ДНК на уровне ферредоксинов производные нитроимидазола (метронидазол) • Ингибиторы синтеза нуклеотидов (нарушение синтеза фолиевой кислоты за счет нарушения метаболизма пуринов и пиримидинов) Противоопухолевые антибиотики подавляют репликацию ДНК.

• Ансамицины (рифамицины) - бактерицидный механизм обусловлен подавлением синтеза РНК путем связывания с ДНК-зависимой РНКполимеразой. Избирательность действия рифампицина связана с тем, что аналогичные ферменты клеток животных менее чувствительны к действию антибиотика. Оказывает бактерицидное действие на микобактерии, грам (+) бактерии, а также гонококки, гемофилы, иерсинии, лептоспиры, бактероиды. При назначении препарата быстро вырабатывается устойчивость.

Резистентность микроорганизмов К антибиотикам

ПРИРОДА АНТИБИОТИКОУСТОЙЧИВОСТИ И ЕЕ МЕХАНИЗМЫ Под устойчивостью микроорганизмов к антибиотикам понимают сохранение их способности к размножению в присутствии концентрации этих веществ, создаваемых при введении терапевтических доз.

Устойчивость микробов к лекарственным препаратам реализуется за счет следующих возможных механизмов: 1. Образование устойчивыми штаммами микроорганизмов специфических ферментов, инактивирующих или разрушающих антибиотики. 2. Изменение проницаемости клеточной стенки или блокирование ее активных транспортных механизмов.

3. Модификация мишени воздействия антибактериальных препаратов (изменение внутриклеточных акцепторов рибосомалъных белков, следствием чего является нарушение связывания антибиотика и т. п. ). 4. Активное выведение антибактериальных препаратов из микробной клетки (эффлюкс). 5. Формирование метаболического «шунта» .

2 типа устойчивости: 1. Природная устойчивость, определяемая свойствами данного вида или рода микроорганизмов. 2. Приобретенная устойчивость (первичная или вторичная).

Механизмы бактериальной устойчивости к различным группам антибиотиков Аминогликозиды Ансамицины Гентамицин, канамицин, тобрамицин и др. Рифампицин β – лактамы Пенициллин, метициллин и др. Фениколы Хлорамфеникол (левомицетин) 1. Перестройка мишени 2. Инактивация антибиотика 1. Активный выброс 2. Перестройка мишени 1. Снижение клеточной проницаемости 2. Перестройка мишени 3. Инактивация антибиотика ферментами 4. Связывание антибиотика бактериальным белком 1. Снижение клеточной проницаемости 2. Активный выброс 3. Инактивация антибиотика ферментами

1. перестройка мишени Гликопептиды Ванкомицин, тейкопланин Макролиды Эритромицин, кларитромицин и др. 1. Активный выброс 2. Перестройка мишени 3. Инактивация антибиотика Тетрациклины Хинолоны и фторхинолоны Сульфаниламиды 1. Снижение клеточной Тетрациклин, проницаемости миноциклин и др. 2. Активный выброс 3. Перестройка мишени 4. Альтернативный путь метаболизма 1. Перестройка ДНК – гиразы Налидиксовая кислота, (мишени) норфлоксацин и др. 2. Нарушение диффузии 3. Активный выброс 1. Активный выброс Ко – тримоксазол и др. 2. Альтернативный метаболизма 3. Гиперпродукция мишени путь

Методы определения чувствительности микроорганизмов к антибиотикам



Спасибо за внимание! Всего Вам доброго!
Антибиотики 2009 сокр. синяя.ppt